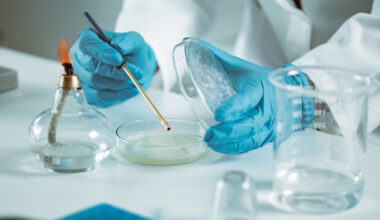

Universe Pharmaceuticals Inc. (NASDAQ:UPC) is a China-based pharmaceutical company that develops, manufactures, markets, and distributes traditional Chinese medicine (TCM) products and other health supplements across Asia. Founded in 1998 and headquartered in Ji’an City, Jiangxi Province, the company operates through its primary subsidiary, Jiangxi Universe Pharmaceuticals Co., Ltd., and has built a vertically integrated business model covering raw material procurement, production, and nationwide distribution. Over the past two decades, Universe Pharmaceuticals has positioned itself as a key player in the modernization of traditional Chinese medicine, combining heritage-based formulations with standardized, science-backed manufacturing processes to meet modern healthcare demands.
The company’s product portfolio encompasses a wide range of TCM-based drugs and dietary supplements aimed at treating common chronic and age-related conditions such as rheumatism, respiratory ailments, cardiovascular diseases, and bone disorders. Its most recognized product lines include pain-relief capsules, anti-inflammatory formulations, and herbal tonics that continue to gain traction in China’s vast domestic healthcare market. To maintain quality and compliance, Universe Pharmaceuticals operates a state-of-the-art GMP-certified manufacturing facility, enabling it to adhere to China’s National Medical Products Administration (NMPA) standards as well as global regulatory expectations for safety and consistency.
Universe Pharmaceuticals’ core business strategy is built around preserving traditional medicinal heritage while expanding into contemporary pharmaceutical innovation. The company has actively invested in R&D and collaborates with local research institutions to refine existing formulations, improve bioavailability, and explore new therapeutic categories. Its approach combines ancient herbal remedies with modern pharmaceutical technology, appealing to both aging populations in China and growing international markets seeking natural, plant-based treatment alternatives.
In 2021, Universe Pharmaceuticals took a major step toward international visibility by listing its shares on the NASDAQ Stock Market under the ticker symbol “UPC.” The listing marked its transition from a regional manufacturer into a publicly traded company with global ambitions. This milestone not only provided access to international capital but also enhanced the company’s brand recognition in the U.S. and other overseas markets. Through this move, Universe Pharmaceuticals aimed to strengthen its financial base, expand its export capabilities, and explore potential partnerships with overseas distributors and biotech firms interested in TCM integration.
Despite its modest scale compared to multinational pharmaceutical giants, Universe Pharmaceuticals has carved out a niche within the global healthcare ecosystem by focusing on preventive medicine and holistic wellness. As China continues to promote the integration of traditional and Western medical systems, Universe stands well-positioned to benefit from government support for the TCM sector, as well as rising demand for herbal products driven by consumers seeking natural, sustainable, and culturally rooted healthcare solutions. The company’s long-standing market presence, manufacturing expertise, and deep product pipeline make it a recognizable name in China’s evolving health products industry.
Today, Universe Pharmaceuticals continues to balance its legacy of traditional medicine with modern market expansion. With a growing distribution network, compliance-driven operations, and a diversified product line, the company remains focused on enhancing accessibility to safe, effective, and affordable therapeutic options rooted in centuries-old wisdom yet powered by contemporary pharmaceutical innovation.
A 56% Surge That Defies Logic
Universe Pharmaceuticals Inc. (NASDAQ:UPC) shocked the market this week as its shares surged 56.09% in after-hours trading, turning what was once a quiet, thinly traded stock into one of the most talked-about names in the biotech microcap space. The sudden spike, which saw UPC jump from just above $4 to nearly $9 within days, created an intense buzz among momentum traders and speculative investors alike. While the rally sparked enthusiasm across online trading communities, it also raised fundamental questions: what exactly is driving the surge, and is it sustainable?
The jump has propelled UPC out of obscurity and into the broader spotlight, but beneath the headline-grabbing volatility lies a company still grappling with significant structural weaknesses. The movement may be less about fundamental strength and more about speculative positioning—a pattern that has frequently ended in sharp reversals for similarly situated penny stocks.

CHECK THIS OUT: Tiziana (TLSA) Surges 143% in 2025 and Immuneering (IMRX) Reports 86% 9-Month Survival in Pancreatic Cancer.
A Closer Look at the Financial Picture
Behind the scenes of this sudden rally, Universe Pharmaceuticals’ financials paint a less promising story. The company reported $23.02 million in revenue, but its growth trajectory remains uneven, with revenue volatility raising concerns about long-term sustainability. While the firm boasts a seemingly impressive revenue per share of around $40.87, its price-to-book ratio sits at an alarming 0.06, suggesting that the market doesn’t value its assets with confidence.
Adding to the complexity is UPC’s leverage ratio of 1.5, which reveals a company heavily dependent on debt to finance its operations. High leverage can amplify gains when business improves—but it also magnifies losses when performance falters. For a small-cap pharmaceutical company with a modest revenue base and limited cash generation, this debt-fueled structure makes it highly vulnerable to market shifts, regulatory setbacks, and operational disruptions.
While investors may find the gross profit margins encouraging, they are only meaningful if the company can sustain positive net earnings—a milestone UPC has yet to consistently achieve. Its prior quarterly filings have revealed recurring operational losses and shrinking gross margins, signaling that the path to profitability is steep and uncertain.
The Speculative Frenzy: What’s Really Fueling the Rally
Analysts believe the 56% price spike could be tied to rumors of corporate developments or potential partnership news, particularly within the pharmaceutical distribution segment in Asia. The company operates primarily in the Chinese traditional medicine and prescription drug markets, where shifts in healthcare policy, seasonal disease trends, or regional government contracts can trigger bursts of speculative interest.
However, no official announcements have been made to justify the magnitude of the move. In such cases, experienced investors often attribute these rallies to momentum-driven trading rather than fundamental catalysts. Small-cap pharmaceutical stocks are notoriously susceptible to algorithmic triggers and social media speculation—once volume surges and retail traders pile in, price acceleration often feeds on itself until liquidity dries up.
This explains why Universe Pharmaceuticals’ chart over the past month looks like a classic short squeeze pattern: low float, sudden volume, and an explosive but potentially fleeting climb. Without verifiable news or substantial financial improvement, the rally could prove ephemeral, leaving latecomers holding heavy losses once the excitement fades.
A Look Back: Performance and Persistent Weaknesses
It’s worth noting that despite the recent rally, UPC’s longer-term performance has been dismal. The stock has plunged more than 90% from its post-IPO levels, reflecting years of operational stagnation, shrinking revenue, and governance challenges. Earlier this year, Universe Pharmaceuticals faced scrutiny for delinquent SEC filings—a serious red flag that prompted Nasdaq to issue a non-compliance notice threatening potential delisting.
These compliance issues raise fundamental doubts about management’s ability to maintain transparent operations and adhere to regulatory standards. For U.S.-listed Chinese pharmaceutical firms, such lapses are particularly damaging, given the heightened skepticism around auditing and reporting practices in overseas entities. Until the company demonstrates consistent regulatory compliance, investor confidence will remain fragile, and its Nasdaq listing status precarious.
Debt Dependence and Balance Sheet Pressure
One of the major risk factors for Universe Pharmaceuticals lies in its debt-heavy balance sheet. The company’s financing model leans heavily on borrowing, exposing it to interest rate risk and repayment pressure. In a tightening monetary environment, where credit conditions are stricter and capital more expensive, UPC’s ability to refinance or service its obligations could become strained.
Additionally, its working capital position remains weak, with limited cash reserves to support research, marketing, or expansion efforts. This lack of liquidity forces the company into a vicious cycle—reliance on short-term debt or equity dilution just to sustain operations. Investors should also be wary of the potential for future share issuances, which could dilute ownership and further depress per-share value.
Operating in an Unforgiving Sector
The pharmaceutical market, especially in Asia, is highly competitive and regulated. Universe faces competition from established state-backed enterprises and multinational pharmaceutical companies with deeper pockets, superior distribution networks, and stronger regulatory relationships. UPC’s focus on traditional Chinese medicine products, while potentially lucrative, also restricts its market appeal internationally due to differences in approval standards and medical classification.
Meanwhile, the global pharma landscape continues to evolve toward innovation-driven therapies—precision medicine, biologics, and digital therapeutics—areas where Universe has limited exposure. Without a clear research pipeline or intellectual property advantage, the company risks being left behind as industry dynamics shift toward science-based differentiation rather than legacy product distribution.
Temporary Pop or Sustainable Turnaround?
The question now facing investors is whether UPC’s latest rally represents the start of a legitimate turnaround or just another speculative bubble. Historically, Universe’s rallies have been short-lived, followed by steep corrections once trading momentum fades. This pattern, coupled with the company’s weak fundamentals, high leverage, and uncertain growth strategy, suggests that the recent gains could evaporate as quickly as they appeared.
While it’s true that small-cap pharmaceutical stocks can experience dramatic short-term spikes driven by event-based speculation, long-term success depends on execution, transparency, and profitability—areas where UPC continues to lag. Unless management provides clear guidance on operational improvements or discloses meaningful partnerships, caution remains the most prudent stance.
Final Thoughts: A Risky Ride for Brave Investors
Universe Pharmaceuticals’ 56% rally may be eye-catching, but it doesn’t erase the company’s underlying challenges. The combination of high debt, declining margins, governance issues, and regulatory uncertainty makes this a high-risk play even for seasoned traders. While short-term traders may find opportunities in its volatility, long-term investors should approach with extreme caution.
In many ways, UPC embodies the classic hallmarks of a speculative penny stock—rapid price action, unclear catalysts, and a fragile balance sheet. Unless the company can back up its price movement with measurable progress in financial health and operational execution, its latest surge could prove to be another fleeting chapter in a long, turbulent history.
For now, Universe Pharmaceuticals remains a story of contrast—one part excitement, one part uncertainty—and perhaps a reminder that not every stock that rises fast is built to stay on top.
READ ALSO: Saudi Arabia Wants CEL-SCI (CVM)’s Multikine Now! and Aligos Therapeutics (ALGS) Doubles Cash to $122.9M.